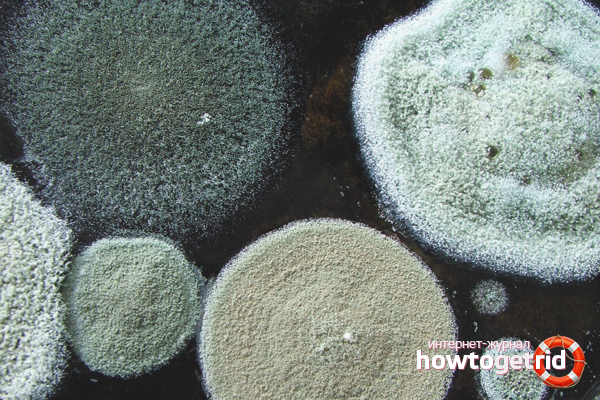
How to get rid of the smell of mold

The content of the article
The first thing that a person entering an apartment pays attention to is the smell. It can be warm, sincere and appetizing if the house smells of fresh pastries and cleanliness. But often, entering the house, we only smell the musty dampness. Not only is it not very pleasant, it is also dangerous. Constant humidity in the air can lead to some diseases of the respiratory system. To avoid this, you need to get rid of the smell of dampness in the apartment as soon as possible.
Where does the damp come from?
No matter how we fight dampness, first you need to determine the source of excess moisture.
- One of the common causes of large amounts of water in a home is the flood. A malfunctioning faucet, a breakdown of the washing machine, a burst pipe - all this can cause water to get directly onto your floor. And this applies not only to your home - with varying success you can be drowned by neighbors from the upper floors.
- Often humidity and dampness are accompanied by large vapors. This means that the hot water pipes came into malfunction.
- If you live on the top floor - the neighbors with the floods are not afraid of you. However, this does not protect you from rainfall - a poor roof will not be able to protect your home from rainwater.
- The dampness on the first floors is most often due to malfunctioning pipes in the basement. You need to go down and check the condition of the entire water system. Permanent leaks are fraught with dampness and washing away the foundation.
- Bad hood or lack thereof. When food is being cooked in the house, this is accompanied by a huge amount of steam and condensation, which settles on the windows and walls. Hence - constant humidity. It is very important when cooking to turn on the hood, especially in the winter season, when all windows are closed.
- Poor ventilation. In old houses, ventilation shafts are often clogged with garbage and foliage. To get rid of dampness and restore air circulation, you need to put them in order.
- End apartments often get damp because they have poor thermal insulation. This is especially noticeable in the winter season, when an obvious temperature contrast is created between the air in the room and on the street. As a result, condensation settles on the walls, forming high humidity.
- Dampness appears in the house if you dry laundry indoors. Whenever possible, try to hang clothes on the street so that excess moisture evaporates outside.
- High humidity is observed in homes with poor heating.
- High humidity may be due to active floriculture. Water evaporates from moist soil and remains in the air. Often in rooms with a flower garden you can feel a persistent smell of dampness.
After a source of dampness has been discovered, it must be eliminated. But it often happens that even after the malfunction is eliminated, a persistent smell of dampness remains in the apartment, which does not disappear.
How to get rid of dampness in an apartment
If condensation drops collect on the windows in the winter, periodically wipe the glass with a rag and do not wait for the moisture to evaporate into the air.
Absorbent materials will help to cope with high humidity. This is coarse salt, activated carbon, baking soda and similar loose substances. It is necessary to pour soda on a plate and put in those places where the smell of dampness is most pronounced. Change the plate with the adsorbing agent as often as possible, as it becomes wet.
After a long stay of the apartment in damp, it is better to dry all textile items - clothes, pillows, bedspreads, blankets, curtains, curtains. Hard objects and coatings should be wiped with a weak solution of vinegar to prevent the development of mold.
How to get rid of a musty smell
Sometimes, even after thorough drying and processing, an unpleasant odor remains in the apartment. To get rid of it, you can buy a room air fragrance. He will create light, unobtrusive aromas in the house.
You can provide pleasant indoor air with the help of improvised means. Fry in a pan of coffee and get a pleasant coffee aroma in your home for the next few days. Drop a few drops of essential oil on any piece of furniture, and your apartment will be filled with the fragrance of peach or almond blossoms.
How to get rid of the smell of mold
Dampness and mold are two friends who rarely appear separately in a house. Where there is dampness, soon mold will certainly appear. To get rid of it, you can use various household cleaning products.
- The joints of the tiles in the bathroom can be cleaned from mold using chlorine-containing bleach. Dilute it with ten parts of water and wipe with this compound all hard surfaces in the bathroom. Be careful with this - wear gloves and a respiratory mask.
- Mold can be under linoleum, under wallpaper, behind a sofa. Spray ammonia, table vinegar or hydrogen peroxide on the affected areas, and after a while wipe off the remaining product with a dry rag.
- During wet cleaning, add a little baking soda to the water. It kills shallow mold spores and suppresses a pungent musty odor.
Mold grows very quickly. To get rid of it, you need to often ventilate the room, eliminate humidity, raise the temperature in the room.
How to get rid of damp in different places of the apartment
You can get rid of dampness in the bathroom with a good heated towel rail. In this case, you need to check the condition of the mine. Do not dry the laundry in the bathroom, but immediately after taking a hot shower, carefully ventilate the room.
A good powerful cooker hood will save you from dampness in the kitchen, which you should not forget to turn it on while cooking. If humidity comes from the basement, it is imperative to eliminate the malfunction in the plumbing system and improve the waterproofing of the basement.
No matter how you create comfort in the house, if it's damp, everything will go down the drain. I don’t want to be in such an apartment - you feel in the basement or train car. You can get rid of high humidity if you put enough effort into it. The main thing is to eliminate the very source of dampness, ensuring comfortable living conditions.
Video: how to get rid of bad smell in the apartment

Submit